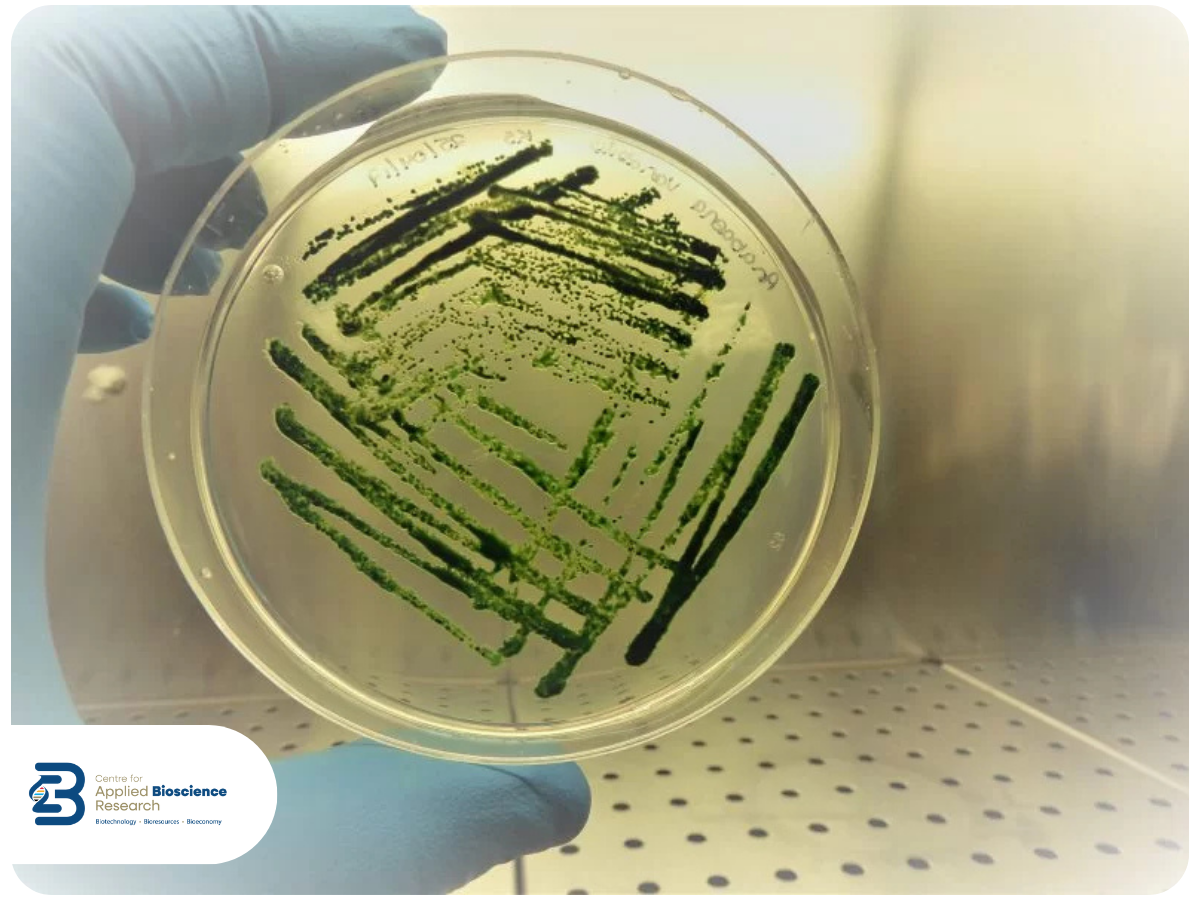
CABR - Microalgal Biotechnology

Microalgal Biotechnology
Microalgae are a group of microscopic organisms capable of growing using light energy. Microalgae represent a significant reservoir of bioactive compounds, nutritional ingredients, and commercial commodities.
Certain microalgal strains, such as Spirulina, are used as food supplements due to their balanced composition of high protein content, vitamin and mineral content, and specific health-beneficial components. However, there are only a handful of microalgae that are approved for use as nutraceuticals. Microalgal biotechnology for nutraceutical applications is a fast-growing segment of the health and nutrition industries. Today, there are tremendous opportunities to use microalgae as a “cell bio-factory” for value-added molecule production and other essential commodities using a biorefinery approach. Eventually, the complete use of microalgal biomass for nutraceuticals, bioenergy production, fertiliser, animal feed, and/or aqua feed, as appropriate, would help in sustainable development and circular bioeconomy.

Establishment of Irish Microalgal Biobank
To unlock the potential of microalgae for biotechnological benefits, we have established a unique biobank of marine cyanobacteria and marine diatoms from selected Irish coasts and microalgae from both freshwater and marine habitats. These biobank strains are being maintained as liquid cultures, agar slants, and cryopreserved for future exploration. Using both conventional and molecular taxonomic approaches, these biobank strains are being characterised. This is an ongoing project towards the continuous growth of the biobank and to conserve biodiversity following identical protocols.

Figure 1 shows the microalgal research activities undertaken at the Centre for Applied Bioscience Research (CABR), starting from strain isolation, identification, and biodiscovery screening through biochemical analysis, optimisation of sustainable cultivation for large-scale biomass generation for biorefinery of target biomolecules and their appropriate applications development.
